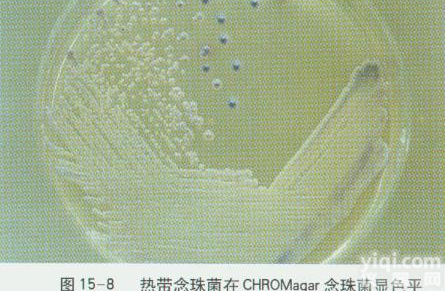
<em>热带</em><em>念珠</em>菌<em>ATCC</em> 750

热带念珠菌 ATCC 750
中文名称:热带假丝酵母
拉丁名称:Candida tropicalis
菌种编号: ATCC 750
来源历史:←美国
收藏时间:2015/8/12
模式菌株:模式菌株
主要用途:分类;研究
特征特性:细胞卵圆形或棒状,单生或对生,无性繁殖为多边芽殖,有假菌丝。
具体用途:分类研究。
培养基名称:5 °Bé麦芽汁琼脂
培养基成分:5°Bé麦芽汁 1.0L,琼脂 15.0g,自然pH。
培养温度:25℃
需氧类型:好氧
保存方法:真空冷冻干燥法
ATCC菌种/ATCC标准菌株/菌种/质控菌株/微生物菌种,低价出售ATCC菌种,CMCC菌种,DSM 菌种,JCM菌种,NBRC菌种,KACC菌种,NCIMB菌种,CBS菌种,部分ATCC 菌种有证书
Candida tropicalis (Castellani) Berkhout, anamorph (ATCC® 750™)
Deposited As Monilia tropicalis (Castellani) Castellani et Chalmers, anamorph
Strain Designations [1909, ATCC 4563, ATCC 7349, CBS 94, CCRC 20520, DSY 59, IFO 1070, IFO 1400, JCM 1541, NRRL Y-12699, NRRL Y-12968, NRRL Y-607]
Application
Assay of chloro-8-quinolinol
Bacterial resistance testing
Degrades xylose D-xylose
Fungus resistance testing adhesives
Produces aspartic proteinases aspartyl proteinases
Produces ethyl alcohol ethanol
Produces xylitol
Susceptibility disc testing
Susceptibility testing
Transformation host
Produces xylitol from D-xylose
Control strain for typing systems 热带念珠菌 ATCC 750
Produces ethanol from D-xylose
Control strain to test oxygen availability in bioreactor in space laboratory
Reference strain for Clinical and Laboratory Standards Institute(CLSI)-developed Antifungal Susceptibility Testing.
Biosafety Level 1
Product Format freeze-dried
Storage Conditions Frozen: -80°C or colder
Freeze-Dried: 2°C to 8°C
Type Strain yes (type strain)
Genotype ade2/ade2 acp/acp delta::lambda/delta::lambda
Preceptrol® yes
Genome Sequenced Strain
Yes
Comments
Fluconazole-sensitive
Utilizes phenol, catechol and 3- and 4-methylcatechols as sole carbon source
Esterase activity
MIC of 2-hydroxychalcone, 75 mcg/ml
Adherence to lysophospholipids
Genome sequencing strain (Genolevures Consortium, France; Wellcome Trust Sanger Institute, UK).
For additional infromation, see CLSI M27-A2 (Reference Method for Broth Dilution Antifungal Susceptibility Testing of Yeasts; Approved Standards-Second Edition).
Mitochondrial genome sequenced strain
Medium ATCC® Medium 200: YM agar or YM broth
ATCC® Medium 1245: YEPD
ATCC® Medium 28: Emmons' modification of Sabouraud's agar
Growth Conditions
Temperature: 25°C
Atmosphere: Typical aerobic
大肠埃希氏菌O157H7 ATCC 35150
金黄色葡萄球菌 ATCC 27217
单核细胞增生李斯特氏菌 ATCC 19114
肺炎克雷伯氏菌 ATCC 10031
小肠结肠炎耶尔森氏菌 ATCC 23715
热带念珠菌 ATCC 13803
克柔假丝酵母菌 ATCC 14243
光滑念珠菌 ATCC 15126
奇异变形杆菌 ATCC 12453
嗜热链球菌 CICC 6038
生孢梭菌 ATCC 19404
黑曲霉 ATCCA 16404
两歧双歧杆菌 CICC 6071 热带念珠菌 ATCC 750
婴儿双歧杆菌 CICC 6069
产气荚膜梭菌 ATCC 13124
阪崎肠杆菌 ATCC 29544
大肠埃希氏菌 8099
大肠埃希氏菌O157 H7 NCTC12900
肺炎克雷伯氏菌 广临检-57
德氏乳杆菌保加利亚亚种 CICC 6032
乙型溶血性链球菌 ATCC 21059
非O1霍乱弧菌 vbo
苏云金芽孢杆菌 ATCC 10792
蕈状芽孢杆菌 ATCC 10206
干酪乳杆菌干酪亚种 ATCC 334
鼠李糖乳杆菌 ATCC 7469
嗜酸乳杆菌 As1.2686
罗伊氏乳杆菌 CICC 6226
嗜热乳酸杆菌 IFFI 6038
迟缓埃格特菌 ATCC 25559
Caldariomyces fumago ATCC 16373
草螺菌 ATCC 35892
绵羊布鲁氏菌 ATCC 25840
肠炎沙门氏菌亚利桑那亚种 ATCC 700155
豕链球菌 ATCC 43138
杨氏柠檬酸杆菌 ATCC 29935
志贺氏菌属 ATCC 12038
肠沙门氏菌肠炎亚种 ATCC 9115
弗氏耶尔森菌 ATCC 33641
丙酸杆菌 ATCC 4875
梅氏弧菌 ATCC 700040
有毒威克斯菌 ATCC 43766
莫拉氏菌属 ATCC 17967
霍利斯格里蒙菌 ATCC 33564
嗜温鞘氨醇杆菌 ATCC 43320
植物乳球菌 ATCC 43199
美人鱼发光杆菌美人鱼亚种 ATCC 33539
耳炎差异球菌 ATCC 51267
杀鲑气单胞菌日本鲑亚种 ATCC 27013
栖冷克吕沃尔菌 ATCC 33435
土生丛毛单胞菌 ATCC 8461
鲇爱德华氏菌 ATCC 33202
马肠链球菌 ATCC 9812
大肠埃希氏菌 O157:H7
大肠埃希氏菌 ATCC 35218
大肠埃希氏菌 ATCC 25922
大肠埃希氏菌 ATCC 44568
大肠埃希氏菌 ATCC 44102
肺炎克雷伯菌 ATCC 700603
肺炎克雷伯菌 ATCC 13883
肺炎克雷伯菌 ATCC 35657
肺炎克雷伯菌 CMCC 46117
铜绿假单胞菌 ATCC 27853
流感嗜血杆菌 ATCC 49247
流感嗜血杆菌 ATCC 9007
乙型副伤寒沙门菌 CMCC 50094
阴沟肠杆菌 ATCC 700323
阴沟肠杆菌 ATCC 700323
阴沟肠杆菌 ATCC 700323
嗜麦芽窄食单胞菌 ATCC 17666
产酸克雷伯菌 ATCC 700324
产酸克雷伯菌 ATCC 700324
木糖氧化产碱杆菌 木糖亚种
热带念珠菌 ATCC 750
非O1群霍乱弧菌 VBO
金黄色葡萄球菌 ATCC 25923
金黄色葡萄球菌 ATCC 29213
金黄色葡萄球菌 ATCC 43300
金黄色葡萄球菌 MRSA
表皮葡萄球菌 ATCC 12228
粪肠球菌(高耐) ATCC 51299
粪肠球菌 ATCC 29212
粪肠球菌 ATCC 33186
淋病奈瑟氏菌 ATCC 49226
淋病奈瑟氏菌 ATCC 19424
淋病奈瑟氏菌 ATCC 19424
肺炎链球菌 ATCC 49619
木糖葡萄球菌 ATCC 35663
铅黄肠球菌 ATCC 700327
温馨提示:不可用于临床ZL。